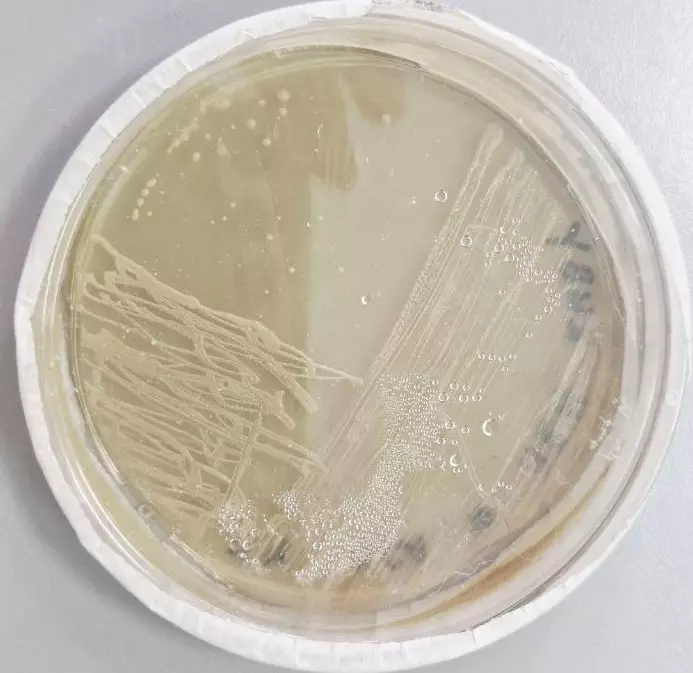

Лекция, посвященная основам биотехнологии растений
На кафедре экобиотехнологии состоялась лекция, посвященная основам биотехнологии растений:
- культивированию клеток и тканей «в пробирке» (in vitro);
- роли фитогормонов в управлении ростом и морфогенезом;
- методам генной инженерии растений и конкретно об агробактериальной трансформации.
Лекция была проведена выпускницей бакалавриата 2024 года направления 19.03.01 Биотехнология и магистранткой 2 курса НИУ ИТМО направления 19.04.01 Индустриальная биотехнология Анастасией Хапугиной.
На лекции рассматривались культуры микроорганизмов вида Agrobacterium rhizogenes с плазмидой, кодирующей ген для окраски тканей растений в красный цвет.
Встреча дала целостное представление о том, как современные биотехнологические подходы используются в науке, сельском хозяйстве и биомедицине.